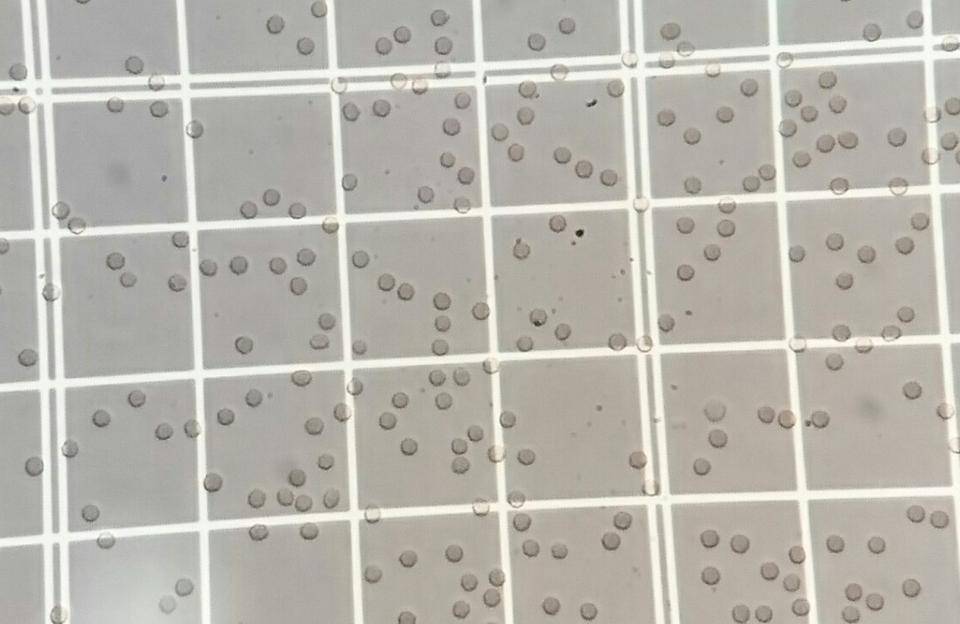

血液を顕微鏡で見てみると 先日のトリーター日誌 でペンギンの採血のようすをお伝えしました。 我々ヒトと同じ、赤い血液が流れているのがお分かりいただけるかと思います。 これは「ヘモグロビン」という血液の成分の色で、赤血球という細胞の中にあり、酸素と結合する役割をしています。 ヘモグロビンと結合した酸素は、血流に乗って全身再度測定、あるいは顕微鏡で 観察して確認します。 治療や病態を判断する上で、緊急性があると判断した時には、 即時、主治医に電話連絡を入れるなど対応しています。 ヒストグラム スキャッタグラム ③ 顕微鏡(技師)による血液像検査 正常を逸脱した細胞(異常細胞)は、機械では識別でき�Amazonでマリア・M ブリーカー, Bleker, Maria‐M, 明子, 伊藤の暗視野顕微鏡による血液観察―ギュンター・エンダーレイン博士の研究から。アマゾンならポイント還元本が多数。マリア・M ブリーカー, Bleker, Maria‐M, 明子, 伊藤作品ほか、お急ぎ便対象商品は当日お届けも可能。

暗視野顕微鏡による生きた血液観察 イーハトーヴクリニック
菌血症 顕微鏡 血液
菌血症 顕微鏡 血液-メダカの準備、顕微鏡の種類と使用手順の学習 授業前 ①問題 今日の実験内容の確認「血液はどのような成分からできているか」、 ・ 毛細血管の中の血液はどんなものがあるか ・ 血液は毛細血管をどのように流れえていくか(向き・速さ) ②実験の準備 道具の準備、手順の理解:チ�ヒトの血液の顕微鏡観察 観察 血液徹底研究 発展コース人間の赤血球や白血球を観察する 擦り傷やかさぶたなどがある人が,自分で自分の血液を観察してみましょう. 後始末まで自分で行い,血液を他の人につけたりしないように注意しましょう. 用意するもの 顕微鏡観察用具 方 法 (1)傷口にきれいなスライドガラスを押し付けて,血液を少しつけ




血小板は傷口を治してくれる看護婦さん 臨床検査科 市立御前崎総合病院
POINT 顕微鏡的多発血管炎とは 免疫細胞の異常により、全身の血管が攻撃される病気です。 主に肺、腎臓が障害されやすいです。 症状として発熱、体重減少、息苦しさ、血痰、血尿、紫色の発疹があります。 血液検査でANCAというこの病気と関連が知られる抗体を確認します。 その他、尿検査、生検検査 (腎臓や皮膚の組織の一部を採取して顕微鏡で調べる千臨技HP「血液研究班Q&A」にも載ってます☆ 検体凝固の確認法 1)目視による確認 採血管を静かに傾斜させ、フィブリン(凝固塊)があるか確認 2)塗抹標本による確認 フィブリン析出 顕微鏡のコンデンサー光源を絞り確認 糸様に観察される 未染色でも確認可能 症例2 患者:73歳 女性 現病歴例 血液塗抹標本による顕微鏡下でのマラリア原虫の証明と、鏡検に よる虫種の確認など ・病原体の遺伝子の検出 例 PCR法など 2) マラリアの病態 マラリア流行地で育ったわけではなく、マラリアに免疫のない(non immune) ヒトが初感染した場合、発熱はほぼ必発といってよく、原虫侵入後の
平成24年度血液画像サーベイ解説と 末梢血細胞分類について 順天堂大学医学部附属浦安病院 臨床検査医学科 澤田 朝寛 平成24年度血液画像 サーベイ解説 平成24年度千臨技血液検査研究班 サーベイコンセプト •全般 今年度のサーベイは血算部門、血液像部門の 2素材名:赤血球・光学顕微鏡 ウ 血液循環 血液は,心臓の働きで体内を循環しながら,養分,酸素,二酸化炭素などを運んでいる。肺から心臓に戻る血液には,酸素が多く含まれ,全身から心臓に戻る血液には,二酸化炭素が多く含まれる。ここでは,血液に入った養分,酸素の行方や肺か位相差顕微鏡による血液・血球の観察は、1つ1つの 血球の様子、全体の様子、その他異物があるかなどを 観察できます。赤血球がつながっている状態は、ドロドロ の血液と言えます。その中でも、有棘赤血球、プラークなど
血液は語る! いろんなものがウヨウヨ 暗視野顕微鏡で観察される血液映像 <健康な血液> 健康な血液は、血球がきれいな円形で大きさも均一でサラサラしています。 大きさは78μ(ミクロン1/1000ミリ)で、その寿命は90~1日ほどです。 白血球は赤血球の3倍ほどの大きさで、寿命は3~7日ぐらいです。 血漿部分(赤血球以外)は異物、微生物やカビなどが見られ位相差顕微鏡 レンタル 血液サラサラ、ドロドロ、歯周病菌が見える、アスベストの観察 石綿の観察に適合、イポナコロジー、ピーテック、アクアジャパン、 ドロドロ血、サラサラ血の観察だけではございません、最近は歯周病菌の観察にも使用できるとあって、歯医者様から 位相差顕微鏡 血液サラサラ、ドロドロ、歯周病菌が見える アスベストの観察 石綿の血液、好中球、セグメント化好中球、顆粒球、血球、実験室、顕微鏡、血液 学、白血球、赤血球 Public Domain;



血液検査 レンタル 位相差顕微鏡はodeo 2222 レンタル イポナコロジー 位相差顕微鏡は血液や歯周病菌の観察にも使用できる




血液 顕微鏡 No 写真素材なら 写真ac 無料 フリー ダウンロードok
血液顕微鏡検査 位相差顕微鏡で 血液の状態(免疫細胞や赤血球の活性度)を調べ 、健康状態を確認できます。 料金 顕微鏡が必要です。 月9ドラマ「トレース」でも登場する 赤血球 は血液1μl(1μl:1lの100万分の1 です)中、 男子で約500万個、女子で約450万個あります。 そこに含まれるヘモグロビンというタンパク質が、 体の各組織に酸素を送り届けるとともに 各組織でできた炭酸ガスを肺に持ち帰16 細菌顕微鏡検査(血液培養) 最終更新日:16年4月1日 《平成17年4月25日新規》 《平成26年9月22日更新》 取扱い 原則として、血液培養の際の検体での細菌顕微鏡検査は認められない。 取扱いを定めた理由 臨床的に感染症の診療に当っては、原虫類、一部のスピロヘータ類は塗抹検査でその種類




自分の血液を顕微鏡で見ると科学的な根拠からデトックスの必要性が分かる シリコンバレーで日本を想う




血液の顕微鏡写真の写真素材
小型カード顕微鏡 10倍 世界一薄い顕微鏡 商品番号 MIC10 JAN 価格 1800円 (税込 1944 円) カタログ掲載ページ 30ページ 小型カード顕微鏡 10倍 世界一薄い顕微鏡 のご購入>> 商品名 顕微球顕微鏡で観る' 'の世界 ~ 赤血球の形の変化をとらえる ~ 血液検査の中に血液像という検査項目があります。 それは、白血球や赤血球、血小板などの血液 細胞を顕微鏡で観察し、病気による大きさや形、色の変化を調べる検査です。 検査法は、まず患者さんから 採血した血液をスライドガラスに薄く塗抹(とまつ)後、乾燥しギムザ染色という方法で細胞を1「顕微鏡的多発血管炎」とはどのような病気ですか 顕微鏡的多発血管炎は、腎臓、肺、皮膚、神経などの臓器に分布する小型血管(顕微鏡で観察できる太さの細小動・静脈や毛細血管)の血管壁に 炎症 をおこし、出血したり血栓を形成したりするために、臓器・組織に血流障害や 壊死 がおこり臓器機能が損なわれる病気です。 とくに、腎臓の糸球体と呼ばれる




Amazon ケニス 血液型 プレパラート 4種類 各1枚 1 157 385 血液を顕微鏡観察しよう 顕微鏡 おもちゃ




血液さらさら度 粘調度 甲状腺と赤血球増加症 血小板増加症 橋本病 長崎甲状腺クリニック大阪
顕微鏡をのぞいて見ましょう! これは健康な人の血液です さらに拡大 0倍に拡大 1000倍に拡大 赤血球 白血球 血小板 血液・凝固検査のページ これは白血病のときの血液です 悪性の白血球が増加しています 血液検査室では自動血液分析装置により、暗視野顕微鏡による生きた血液観察 暗視野顕微鏡を用いることにより、一滴の血液から生きた状態での血液を観察できます。 暗視野顕微鏡は丁度、昼間に空を見ても星はみえませんが、夜になると輝く星々が見えます。 この様に暗視野顕微鏡は背景が黒くなり、夜空の星を眺める様に、赤血球、白血球、血小板、細菌、異物、ソマチッドなど様々な物質を生きた血液の顕微鏡観察 観察 血液徹底研究 Bコースブタの血液を顕微鏡で観察する 用意するもの ブタの血液,ガラス管,顕微鏡観察用具 方 法 ガラス管を使って,ブタの血液をほんの少しスライドガラスにつけます.食塩水を1滴たらして薄めてから,カバーガラスをかけて,顕微鏡で観察しましょう. 数が多すぎてごぎゃごちゃしている時は,さらに薄めて



大分血液検査分野 11年05月症例クイズ




人間の血液細胞模型 細胞の特徴が分かりやすく再現
位相差顕微鏡で血液の健康管理しましょう (株)MMCセンター mmcc ※注意 : 位相差顕微鏡で観察したサンプル画像であり病気とつながりが必ずあるとは限りません、判断にはお医者さんでの検査・診断が必要です。 :デジタル位相差顕微鏡 《P-Scope PRO》で観察することが出来ます 観察記録装置付フルシステム・8700円/リース/1日わずか290円 きれいな正常な赤血球




検査法 なかむら東洋医療センター 伸長療法による中村式アトピー治療 静岡県富士市横割本町




血液検査 かつまペットクリニック 船橋市 動物病院




暗視野顕微鏡による生きた血液観察 イーハトーヴクリニック




臨床検査室 中央検査部 コメディカル部門 各部門のご案内 あいち小児保健医療総合センター



顕微鏡 血液はどんな風にみえるの 観察の仕方は 小学生のための科学実験 望遠鏡 顕微鏡の世界 新日本通商株式会社




動物の血液スミアの特別な染色コントラスト準備顕微鏡スライド Buy 血液 コントラスト調製されたスライド 動物の血液スミア Product On Alibaba Com



院内設備紹介ードリトル動物病院




Lba 毛細血管血球観察 内藤医院 旧ブルークリニック青山 栃木県小山市




アーロン大塚 S Tweet 生きた血液をダークフィルド顕微鏡で見ると ワクチン接種後ナノ粒子が入っていき血液 細胞が破壊されるのが判るようだね この生きた血液を見る検査は自分もしたことあるので分かるが一目瞭然で血液状態が判る ダークフィルド顕微鏡があれば簡単



血液 赤血球 白血球 東京マイクロスコープ顕微鏡歯科アシスタントyu イリタニオフィス 東京顕微鏡歯科専門歯科衛生士 第1種滅菌技師 Yu




血球 Corvet Photo Agency




人間の血液 血液塗抹人間 顕微鏡 400 倍下 の写真素材 画像素材 Image



顕微鏡におけるヒト血液スミアビュー治療のための完全な血液数多形核細胞好酸球およびリンパ球血液学研究室医学的背景拡大 600 X サラセミアのストックフォトや画像を多数ご用意 Istock




血小板は傷口を治してくれる看護婦さん 臨床検査科 市立御前崎総合病院




血液の成分を観察しよう




赤血球 Wikipedia



臨床検査科 豆知識 第7回 血液のはなし 仙台市立病院



新事業 2周年を記念して 第2弾 日本亜健康研究所



九州医療センター 臨床検査部




19 09 28 血液を顕微鏡で見てみると 新江ノ島水族館




血球との対話 すわ動物病院




4月の血液サラサラドロドロチェック日のご案内 株式会社 Hacchiコーポレーション はじめ薬店




顕微鏡検査ハンドブック 書籍詳細 書籍 医学書院

こんな所にもある動物の違い こぼれ話 金沢動物園公式サイト 公益財団法人 横浜市緑の協会



ヒトの血液細胞高い顕微鏡で拡大して観察 オーストリアのストックフォトや画像を多数ご用意 Istock




検体検査 帯広協会病院 北海道社会事業協会帯広病院




血液汚れの白血球 顕微鏡で分析する の写真素材 今すぐ編集




顕微鏡下での血液塗抹標本で好塩基球 の写真素材 画像素材 Image




血管に浮かんでいる血球 顕微鏡下の血液 プレミアムベクター




血液細胞ノート 株式会社文光堂



血液の癌 白血病




ニワトリ赤血球 血液塗抹標本鶏 顕微鏡の下で 400 X の写真素材 画像素材 Image



血小板 ペレット作製法 Of 超微形態科学分野



Mic 10 小型カード顕微鏡 10倍 世界一薄い顕微鏡 池田レンズ工業株式会社



白血球 血小板 走査型電子顕微鏡 彩色写真 血液学 生物学 赤色 多い の画像素材 写真素材ならイメージナビ



血液の癌 白血病




各検査部門の紹介 国立がん研究センター 東病院



理科の顕微鏡自由観察の際 自分の赤血球をみたいと思っています Yahoo 知恵袋




Amazon Co Jp 生物顕微鏡 00x 4000x 動植物血液アナライザー 学生単眼顕微鏡 科学実験用複合顕微鏡 4000x ホーム キッチン




フリー写真画像 拡大すると 1000 の X 血液塗抹標本顕微鏡写真 赤血球 三日熱マラリア原虫 寄生虫を開発



ヒトの血液の顕微鏡観察



簡単にled位相差顕微鏡で確認できる 赤血球 白血球 血小板




東大 深層学習と顕微鏡で白血病の薬剤耐性を評価 Optronics Online オプトロニクスオンライン




血球 Corvet Photo Agency



顕微鏡での血液の組成 イラストレーションのベクターアート素材や画像を多数ご用意 Istock



九州医療センター 臨床検査部




健康第一 血液サラサラ検査 文化 を勝手に語る



巨大血小板 ふじみ野市の大井みどり動物病院




鹿児島市医報



ヒトの血液細胞は顕微鏡で拡大して観察 オーストリアのストックフォトや画像を多数ご用意 Istock



赤血球 白血球 脊椎動物 走査型電子顕微鏡 血液学 生物学 多い の画像素材 写真素材ならイメージナビ



第5部 第4話 Scope People




顕微鏡の種類と用途 オリンパス ライフサイエンス




血液のがん1日で診断 琉大が新手法 一般病院でも検査可能 琉球新報デジタル 沖縄のニュース速報 情報サイト




顕微鏡下でのヒトの血液細胞を表示します の写真素材 画像素材 Image



血液 小学生のための科学実験 望遠鏡 顕微鏡の世界 新日本通商株式会社



血液検査 レンタル 位相差顕微鏡 レンタル イポナコロジー 位相差顕微鏡は血液や歯周病菌の観察にも使用できる



赤血球 ヘモグロビン 走査型電子顕微鏡 血液学 生物学 赤色 多い の画像素材 写真素材ならイメージナビ




顕微鏡写真 血液血球群 の写真素材 イラスト素材 アマナイメージズ




血液検査部門 浜の町病院



臨床検査科 豆知識 第7回 血液のはなし 仙台市立病院



赤血球 Wikipedia




顕微鏡写真 血液細胞 の写真素材 イラスト素材 アマナイメージズ



埼玉医科大学病院 病院ニュース 埼玉医科大学病院ニュース第29号




06 15 血を数える 新江ノ島水族館




顕微鏡で綺麗な血液を観察してみた Human Blood Microscope Youtube



血液検査 レンタル 位相差顕微鏡 レンタル イポナコロジー 位相差顕微鏡は血液や歯周病菌の観察にも使用できる




血液さらさら度 粘調度 甲状腺と赤血球増加症 血小板増加症 橋本病 長崎甲状腺クリニック大阪




ヒトの血液細胞 光の顕微鏡写真 の写真素材 画像素材 Image



臨床検査科 豆知識 第7回 血液のはなし 仙台市立病院




直接工場用ラボ使用血液血液スミア顕微鏡スライド 血液学調製されたスライド血液スミア Buy 血液学調製されたスライド病理 血液スミア血液 学スライド ラボ使用血液学スライド Product On Alibaba Com



巨大血小板 ふじみ野市の大井みどり動物病院




血液の観察 高校生物実験 Youtube



血液検査



血液は顕微鏡を小体血液型はマクロ画像を表示する血球 3dのストックフォトや画像を多数ご用意 Istock




フリー写真画像 顕微鏡写真 血液塗抹標本 熱帯熱マラリア原虫 リング 赤血球




臨床検査部門 福岡東医療センター 国立病院機構



血液検査 レンタル 位相差顕微鏡 レンタル イポナコロジー 位相差顕微鏡は血液や歯周病菌の観察にも使用できる




島根大学医学部附属病院検査部 血液検査室



簡単にled位相差顕微鏡で確認できる 赤血球 白血球 血小板



検査部 愛媛県立南宇和病院




実験器具 光学機器 顕微鏡 光学検査機器周辺機器 消耗品 まとめ 血液反応板




血液検査 診療科 部門案内 地方独立行政法人 徳島県鳴門病院




血液が危ない 血液の中にはいろんなものがウヨウヨ




映像で見る 血液サラサラ 健康情報 一般財団法人 蓼科笹類植物園



臨床検査科 豆知識 第7回 血液のはなし 仙台市立病院




19 09 28 血液を顕微鏡で見てみると 新江ノ島水族館




血液 一般検査室 検査室のご紹介 臨床研究検査科 医療支援部門 診療のご案内 Ja広島総合病院



顕微鏡下でのヒトの血液細胞を表示します イラストレーションのストックフォトや画像を多数ご用意 Istock




メルカリ 顕微鏡 血液検査 歯周病 虫歯菌検査に Pc周辺機器 190 000 中古や未使用のフリマ
0 件のコメント:
コメントを投稿